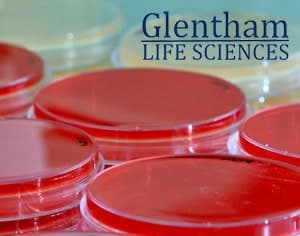
Glentham Life Sciences : Découvrez la gamme d'acides aminés
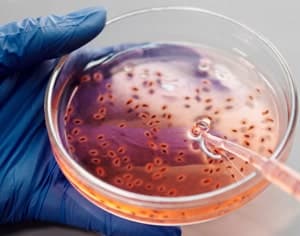
Journée mondiale de la sclérose en plaques : une opportunité pour sensibiliser et éduquer sur cett…

22 juillet. Journée mondiale du cerveau
22 juillet 2024
La Journée mondiale du cerveau est célébrée chaque année le 22 juillet dans le but de sensibiliser la société à l'importance de cet organe vital et de promouvoir la recherche en neurosciences.Le cerveau est le centre de contrôle de toutes les fonctions corporelles et cognitives, responsable de notre...

Réactifs de laboratoire de différentes marques : Thermo Scientific, Indagoo, Apollo, TCI, Reagecon, SRL
19 juillet 2024
Chez CymitQuimica, nous proposons une grande variété de marques qui fournissent des réactifs chimiques essentiels pour la recherche dans vos laboratoires. Les réactifs chimiques suivants sont utilisés dans diverses applications scientifiques, telles que la synthèse organique, l'analyse chimique et l...

Découvrir le vaste catalogue de SRL
19 juillet 2024
Sisco Research Laboratories (SRL) offre des produits chimiques de laboratoire de haute qualité. Pour garantir les meilleurs réactifs, milieux de culture microbiologique et outils de protéines et ADN de Biolit, SRL a mis en place un système de gestion conforme aux normes ISO 9001:2015, ISO 17025:2017...

Standards de spectroscopie : Apollo Scientific
15 juillet 2024
En spectrophotométrie, un standard désigne une substance de référence avec une concentration connue et bien définie, utilisée pour calibrer ou vérifier la précision d'un spectrophotomètre. Les standards spectrophotométriques sont essentiels pour garantir des mesures précises et reproductibles de l'a...

Produits pour la Science des Matériaux d'Indagoo
11 juillet 2024
La science des matériaux est l'étude des propriétés des matériaux solides, qui sont déterminées par la composition et la structure du matériau.Avec Indagoo Research Chemicals, vous pouvez trouver une large gamme de composés prêts à être utilisés dans les laboratoires de science des matériaux pour la...

Glentham Life Sciences : Découvrez la gamme d'acides aminés
3 juillet 2024
En utilisant son expertise scientifique et industrielle pour fournir des produits chimiques de la plus haute qualité pour les travaux de recherche et de laboratoire, Glentham Life Sciences garantit la qualité et la sécurité de ses produits, qui sont tous conformes à la norme ISO 9001.Parmi eux, vous...

Lipides, composés clés pour le système biologique
2 juillet 2024
Les lipides sont des molécules principalement composées de carbone, d'hydrogène et, dans une moindre mesure, d'oxygène. De plus, ils peuvent contenir du phosphore, du soufre et de l'azote. Ces substances ne se dissolvent pas dans l'eau, mais se dissolvent dans des solvants organiques.Larodan, l'une ...

Dépannage de l'expérience ELISA : Analyse des problèmes courants et des causes
27 juin 2024
Les kits ELISA de ELK sont connus pour leur large gamme d'indicateurs et leur intégrité exceptionnelle, disponibles en milliers d'unités. Ils présentent une haute précision avec des valeurs de coefficient de variation (CV) intra-test et inter-test inférieures à 10 % et un taux de réaction croisée de...

Tout ce que vous devez savoir sur la Pharmacopée
20 juin 2024
Qu'est-ce qu'une pharmacopée et une norme pharmacopée ?Une pharmacopée est un recueil officiel contenant des normes et des spécifications pour la qualité, la pureté, le dosage et les méthodes de préparation des médicaments et des substances pharmaceutiques. C'est une référence essentielle pour les p...

PhytoLab, votre partenaire idéal pour les services analytiques
17 juin 2024
Nous souhaitons vous présenter PhytoLab, un laboratoire de tests indépendant et accrédité spécialisé dans les produits médicinaux à base de plantes, les denrées alimentaires, la nutrition animale et les cosmétiques.En tant que membre du Nature Network, Phytolab se consacre à garantir la qualité, l'e...

Les catalyseurs hétérogènes de STREM et leurs principaux avantages
14 juin 2024
Les catalyseurs jouent un rôle crucial en chimie. Un catalyseur peut être utilisé pour accélérer la vitesse d'une réaction en abaissant l'énergie d'activation, offrant ainsi une voie alternative pour que le processus se produise, appelée catalyse. De plus, ils peuvent influencer la sélectivité des r...

Familles de produits d'Extrasynthese, notre partenaire clé
10 juin 2024
En tant que partenaire clé, Extrasynthese apporte plus de 30 ans d'expertise, avec un portefeuille diversifié de plus de 1000 références. Leurs offres incluent quatre familles de produits distinctes : Standards Analytiques Phytochimiques, Matériaux de Référence Botaniques (BRM), Extraits de Référenc...

Indicateurs Chimiques de Reagecon
7 juin 2024
Il est important de sélectionner l'indicateur approprié selon la gamme de pH ou les propriétés redox nécessaires pour l'analyse spécifique dans votre laboratoire.Voici une liste des indicateurs chimiques de Reagecon actuellement disponibles sur notre site Web CymitQuimica, incluant à la fois des ind...

4 juin, Journée Mondiale de la Fertilité
4 juin 2024
Le 4 juin marque la Journée de la Sensibilisation à la Fertilité, une journée dédiée à mettre en lumière le problème croissant de l'infertilité et les avancées dans la recherche et les traitements visant à aider les couples à concevoir. En cette journée, il est essentiel de comprendre l'incidence de...

Journée mondiale de la sclérose en plaques : une opportunité pour sensibiliser et éduquer sur cette maladie
30 mai 2024
Chaque année, le 30 mai, on célèbre la Journée mondiale de la sclérose en plaques, une date importante pour sensibiliser la société à cette maladie qui affecte des millions de personnes dans le monde entier. La sclérose en plaques est une maladie chronique et auto-immune qui affecte le système nerve...

Découvrez la solution fiable pour relever les défis des PFAS, avec LGC
29 mai 2024
Les substances per- et polyfluoroalkylées (PFAS), une classe de produits chimiques dangereux, posent des problèmes environnementaux et sanitaires en raison de leur présence généralisée dans divers produits tels que les pesticides, les cosmétiques, les emballages alimentaires, les revêtements antiadh...

Exploration de Apollo Scientific
22 mai 2024
Chez CymitQuimica, nous sommes ravis de présenter l'une de nos marques phares, Apollo Scientific. Avec une gamme complète couvrant plus de 90 000 produits chimiques, 6 000 produits en sciences de la vie et une variété d'éléments essentiels en spectroscopie, Apollo Scientific continue d'être une dest...

Compréhension des Impuretés API et leur Importance dans l'Industrie Pharmaceutique
16 mai 2024
Les impuretés dans les produits pharmaceutiques sont des substances chimiques indésirables qui restent dans les principes actifs (API) ou se développent pendant la fabrication ou apparaissent en raison de la dégradation de la molécule elle-même. La présence de ces substances chimiques indésirables, ...

Produits Indagoo : Innovation garantie
7 mai 2024
Indagoo Research Chemicals se distingue comme fournisseur leader de composants de base pour composants chimiques et biochimiques de première qualité, avec un portefeuille de plus de 10 000 produits. Les chercheurs comptent sur leurs outils pour accélérer et optimiser leurs processus de laboratoire, ...
29 avril, Journée Internationale de l'Immunologie
29 avril 2024
Le 29 avril se célèbre la Journée Internationale de l'Immunologie, une journée dédiée à explorer et célébrer un domaine crucial dans le monde de la science, axé sur le système immunitaire et ses fonctions vitales pour la santé humaine. Pour mieux comprendre cette journée et sa signification, il est ...